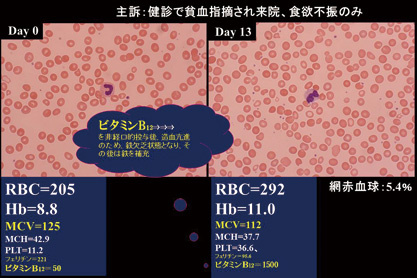
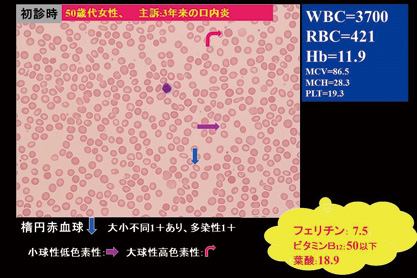

=== 随筆・その他 ===
|
| 血清ビタミンB12値が50以下とは? |
東区・郡元支部
(デイジークリニック) 武元 良整 |
|
ビタミンB12が低値であれば,大球性貧血というのがすぐ,頭に浮かぶでしょう。MCV(Mean Corpuscular Volume:平均赤血球容積)の正常値は90.0です1)。ビタミンB12が低値で,MCV値が100以上になる大球性貧血(症例1. Hb:8.8,MCV:125)の典型例が悪性貧血です。抗内因子抗体が陽性で診断が確定します。ただし,この検査は保険適応外で,自己負担となります。教科書によると,悪性貧血例は血液専門病院の外来に,3年間で1例の来院頻度と記載される疾患です2)。今回は外来で遭遇した2例のビタミンB12低値例を呈示いたします。
<悪性貧血の1例>
症 例 1:70歳代の女性
主訴:健診で貧血指摘され来院。食欲不振あり。
病歴:数年前から健診で貧血指摘されていた。ピロリ除菌後。毛染め後で白髪なし。
背景:飲酒,喫煙歴なし。高血圧,脂質異常症,糖尿病にて加療中。大腸憩室あり。身長,162.9cm,体重52.0kg,BMI:19.5。
末梢血検査:CBC:全血算(complete blood count)
| WBC:3600/μL,RBC:205万/μL,Hb:8.8g/dL,MCV (mean corpuscular volume:平均赤血球容積):125f L,MCH(mean corpuscular hemoglobin:平均赤血球血色素値):42.9pg,PLT(血小板数):11.2万/μL,網赤血球:1.4% |
経過:血液生化学検査にてビタミンB12低値(50pg/mL以下)を認めた。LDH高値(324 IU/L)と溶血も示唆されます。内因子抗体は陽性にて悪性貧血と診断。非経口的ビタミンB12治療を開始し治療開始2週間後には以下のようにHb増加し網赤血球増加がみられました。
| WBC:5800/μL,RBC:292万/μL,Hb:11.0g/dL,MCV:112f L,MCH:37.7pg,PLT:36.6万/μL,網赤血球:5.4% |
最終診断:悪性貧血
|
図 1 末梢血液像-大小不同2+あり,多染性1+
(末梢血液画像は鹿児島市医師会臨床検査センター血液検査室へ依頼し撮影いただきました) |
<胃切除後貧血の1例>
症 例 2:50歳代の女性
主訴:3年間,2週間毎に繰り返す口内炎。
病歴:12年前に胃がんにて胃全摘受けた。ネットで調べて,胃切除後のビタミンB12欠乏などを心配して来院。
背景:疲労,あざができやすい,体重減少そして頭痛等あり。非喫煙・飲酒せず,ヨガを毎週。
末梢血検査:CBC
| WBC:3700/μL,RBC:421万/μL,Hb:11.9g/dL,MCV:86.5f L,MCH:28.3pg,PLT:19.3万/μL,網赤血球:1.1% |
経過:血液生化学検査にてビタミンB12低値(50pg/mL以下)と低フェリチン(7.5ng/dL)を認めた。口内炎は鉄剤とビタミンB12投与後に消失,現在まで口内炎の再燃なし。といったこれまでの治療方法だけではなく,海外では標的抗体薬のリツキシマブも使用されています。
|
図 2 末梢血液像-楕円RBCs・棒状RBCsは鉄不足を示す。
小球性低色素性,大球性高色素性RBCsの散在あり。
(末梢血液画像は鹿児島市医師会臨床検査センター血液検査室へ依頼し撮影いただきました) |
終わりに
2例共にビタミンB12値が50以下と高度に低下。症例1はMCVが125で典型的な悪性貧血例,フェリチン値は正常。理解しにくいのは症例2.のような胃全摘後のビタミンB12欠乏(ビタミンB12は数年間の貯蓄があるため,すぐには低下しない)と鉄欠乏の合併です。
症例2のMCV値(86.5)はあくまでも平均値とご理解ください。ビタミンB12低値とフェリチン低値の影響で血液像には楕円赤血球・棒状赤血球・小球性低色素性・大球性高色素性赤血球が混在し病態の多様性を示しています。
文 献 1. 後藤明彦:末梢血検査と貧血の鑑別 最新医学 別冊号 125:66-73. 2017
2. 柴田 進:図解血液病学 P118-123,金芳堂(京都)1988.

|
|
このサイトの文章、画像などを許可なく保存、転載する事を禁止します。
(C)Kagoshima City Medical Association 2017 |